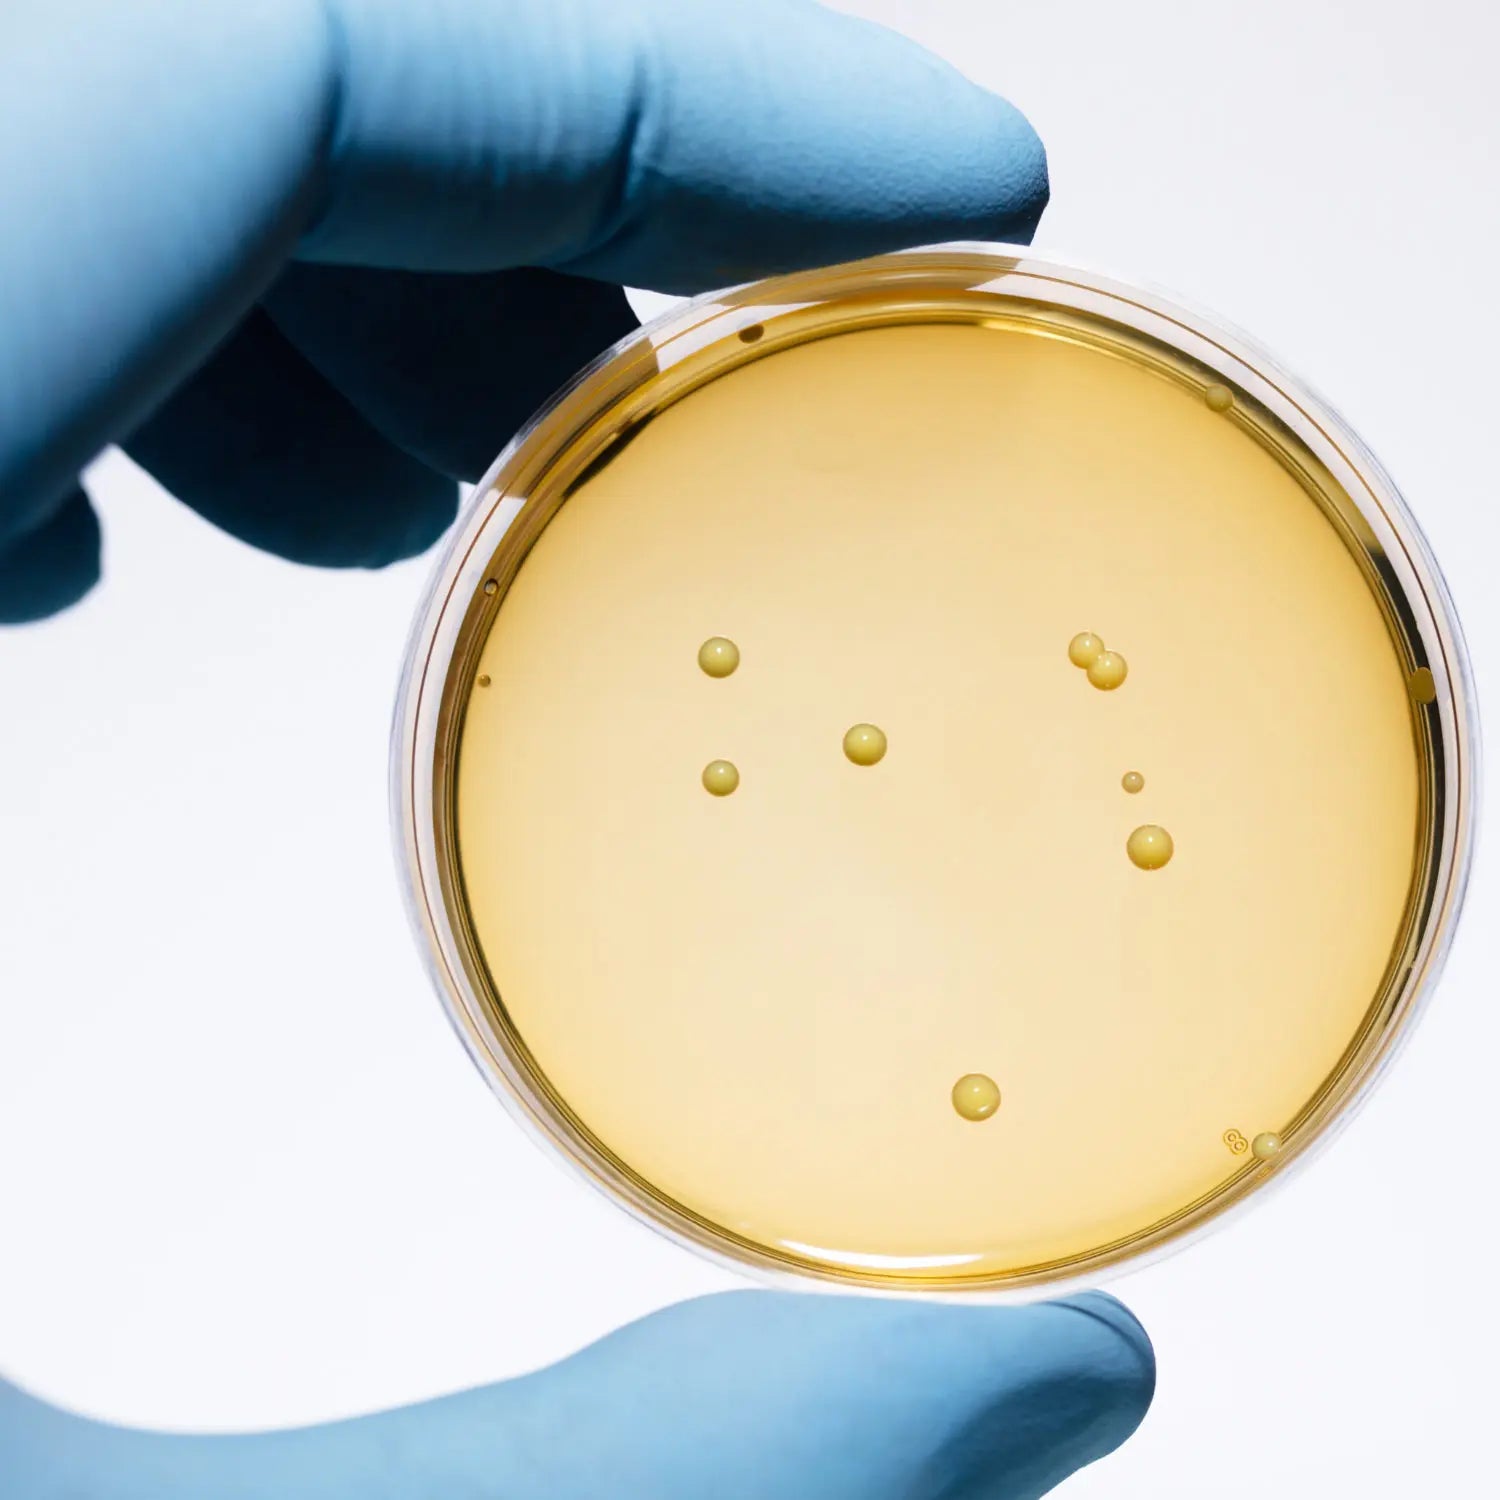

PeeWee Holzstreu – Natürliches, nachhaltiges Katzenstreu aus Holzpellets

durchschnittliche Streukosten nur 4€/Monat

klimaneutral

82% weniger e.coli Bakterien Wachstum

geruchsbindend

staubfrei

Feuchtigkeitsaufnahme bis zum 15-fachen Volumen
-
14 L / 9 KG PeeWee Holzstreu Katzenstreu Einstreu Bio Öko Streu Pellets 14 L / 9 KG PeeWee Holzstreu Katzenstreu Einstreu Bio Öko Streu Pellets
€14,9514 L / 9 KG PeeWee Holzstreu Katzenstreu Einstreu Bio Öko Streu Pellets
€14,95 Grundpreis €1,07/l -
28 L / 18 KG PeeWee Holzstreu Katzenstreu Einstreu Bio Öko Streu Pellets (2x9kg) 28 L / 18 KG PeeWee Holzstreu Katzenstreu Einstreu Bio Öko Streu Pellets (2x9kg)
€27,9528 L / 18 KG PeeWee Holzstreu Katzenstreu Einstreu Bio Öko Streu Pellets (2x9kg)
€27,95 Grundpreis €1,00/l -
42 L / 27 KG PeeWee Holzstreu Katzenstreu Einstreu Bio Öko Streu Pellets (3x9kg) 42 L / 27 KG PeeWee Holzstreu Katzenstreu Einstreu Bio Öko Streu Pellets (3x9kg)
€40,9542 L / 27 KG PeeWee Holzstreu Katzenstreu Einstreu Bio Öko Streu Pellets (3x9kg)
€40,95 Grundpreis €0,98/l

Pfoten bleiben sauber und trocken
Sägemehl und Streu bleiben nicht an den Pfoten oder im Fell kleben. So hast du nicht nur eine saubere Katze, sondern auch endlich keinen Katzenklostaub mehr im Haus. Lästige Katzenstreureste gehören der Vergangenheit an. Dein Haus bleibt bemerkenswert frisch und sauber.
Ammoniakgeruch wird vollständig absorbiert
PeeWee-Holzstreu hat die einzigartige Eigenschaft, dass es Ammoniakgeruch neutralisiert und erheblich mehr Feuchtigkeit absorbiert als alle anderen im Markt erhältlichen Katzenklofüllungen, und zwar bis zum 15-fachen ihres eigenen Volumens!

Wissenschaftlich bestätigt
Eine von PeeWee 2018 in Auftrag gegebene Studie des nationalen schwedischen Forschungsinstituts (RISE AB) ergab, dass das Wachstum von E. coli-Bakterien bei PeeWee-Holzpellets im Vergleich zu herkömmlicher Bentonitstreu um 82 % reduziert ist.
Zu 100% aus Sägespänen schwedischer Nadelhölzer hergestellt
PeeWee-Holzstreu wird aus den reinen Sägespänen ausgewählter schwedischer Nadelholzsorten, ohne Rinde oder Blatt, hergestellt. Die Sägespäne sind ein Restprodukt der FSC-zertifizierten Forstwirtschaft in Nordschweden, wo Bäume aufgrund der Kälte langsamer wachsen und eine spezielle Holzstruktur aufweisen. Diesem Umstand verdankt das PeeWee-Holzstreu seine spezifischen Eigenschaften.


100% natürlich und kompostierbar
PeeWee-Holzstreu ist sicher für Katze & Mensch: Unser Streu ist aus 100 % erneuerbaren Rohstoffen hergestellt und ist 100 % abbaubar. In einem einzigartigen Verfahren werden die Sägespäne ohne Verwendung von Leim oder chemischen Zusätzen zu Streu gepresst. Unser Streu ist darüber hinaus unempfindlich gegen Schimmel und Frost.
Extrem ergiebig und sparsam
PeeWee Holzstreu ist extrem ergiebig. In Kombination mit dem PeeWee Katzenklosystem reicht ein 9 Kilo Beutel bei einem 1-Katzen Haushalt ganze 4 Monate.
Die monatlichen Streukosten liegen somit bei durchschnittlich 3,99 Euro.

Unsere PeeWee Produktpalette

PeeWee Starterpakete

Ersatzteile & Zubehör